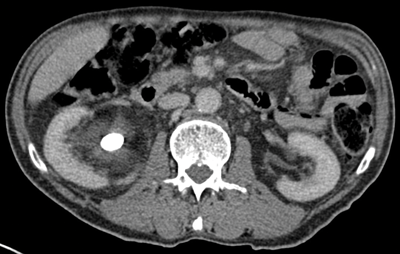

Introduction
Unenhanced computed tomography of kidneys, ureter and bladder (CTKUB) is the recommended gold standard investigation in patients with acute renal colic. CT urography is now a commonly used technique in the investigation of haematuria, for surgical planning and for upper tract surveillance in patients with known transitional cell carcinoma. When CT is performed, it is usually reformatted, and viewed, on standard abdominal windows settings.
There are different windows, widths and levels that give a different appearance to the same image, and enable different structures to be visualised. Abdominal, or soft tissue windows enable clear visualisation of the soft tissues within the abdomen, compared with bone windows that enable the interpreter to examine the internal structure of the bones.
This article illustrates a few cases where a lesion or abnormality is more clearly seen on bone, rather than abdominal windows.
“In urology imaging, bone windows can be used in several different settings, but are particularly useful in stone imaging.”
Window settings
Every CT image contains more information than can be displayed on one window width and level setting. This is described in basic terms below to explain the differences between the window width and level and how this makes the same image look different in order to delineate different structures. A basic description of window width and level is given below.
The window width describes the range of Hounsfield Units (HU) displayed and ranged from 1 to 2000 or 3000 depending on the type of CT scanner. Lowest HU in the window range are black and the highest are white. Human eyes are not capable of distinguishing this many shades of grey, but are able to distinguish approximately 16 shades so the window width is divided by 16 and each group of HU values is converted to one of 16 shades of grey.
The window level is the HU, which is the central value of the window used for the display of the CT images, i.e. the window width.
Abdominal windows are largely for soft tissues so most of the structures have HU ranging from 0-100. Typical abdominal window setting is width 400, level 50. A total range of 400 different densities is seen, centred on a density of 50HU. Each group of 25HU (400/16) is shown as a different shade of grey.
Bone window settings are window width 2000, window level 250. The window width is high, so a wide range of densities are seen in only 16 shades of grey, making the contrast very low.
There is usually a setting to alter the window width and levels, and as you drag the mouse to the right, the width increases and dragging the mouse down decreases the window level.
PACS (picture archiving and communication system) monitors generally have a shortcut key for each of the window settings, allowing the interpreter to easily change from one window setting to another.
Other window settings are available, including liver, brain and lung settings but these will not be covered in this review.
The figures shown demonstrate the difference in appearance of a CT abdomen in abdominal and bone window settings as well as the relevant pathology.
Use of window settings
In urology imaging, bone windows can be used in several different settings, but are particularly useful in stone imaging. Examples of different pathologies are shown with the abdominal and bone windows given for the same CT slice in order to demonstrate how bone windows can be helpful in the CT assessment.
Stents or nephrostomy tubes
A ureteric stent or nephrostomy tube is seen as very highly attenuating (bright) on CT using both abdominal and bone windows. However, the HU of a stent or nephrostomy when measured is higher than that of most calculi. This is due to the composition of the material of the stent or nephrostomy tube.
The stone alongside the stent may be masked using abdominal windows, but when changed to bone windows, the stone can be clearly seen due to the difference in HU of the stone compared with the stent (Figure 1) [1].

Figure 1a: Abdominal windows stone and stent.

Figure 1b: Bone windows stone and stent.
This allows a stent or nephrostomy tube to be distinguished from a calculus [2] and can help aid further patient management.
Stone size
Studies have been performed showing that using magnified bone window settings is more accurate in measurement of stone size than standard abdominal settings [3]. This study was undertaken using hand calipers to measure stones once they had passed and comparing the measurements to CT using abdominal windows and magnified bone window settings. Treatment of a stone may depend on the size, and measuring it with the most accurate method is obviously ideal.

Figure 2a: Abdominal windows stone with contrast.

Figure 2b: Bone windows stone with contrast.
CT urograms can be performed with a pre-contrast CTKUB to assess for stone disease and calcification, but some centres only perform a post-contrast urographic phase in order to decrease radiation dose. Newer dual-energy CT scanners include software that enables a ‘virtual pre-contrast CT’ to be reconstructed by a subtraction technique. Using bone windows enables some calculi to be visualised even in the presence of contrast in the collecting systems due to the different HU values of contrast and calculi (Figure 2). However, it can be difficult to clearly depict some calculi using abdominal windows in this group of patients as the stone will be masked by the excreted contrast.
Stone fragility
CT can be used to assess the internal structure of calculi, which is best seen using bone windows [4] compared with abdominal windows where the stone may appear homogeneous. Some studies have shown that heterogeneous calculi are more fragile leading to better fragmentation with treatment, as the irregularities seen within the calculus act as focal spots for shock wave treatment, leading to better fragmentation of the stone [5] (Figure 3).
Figure 3a: Abdominal windows stone fragility.

Figure 3b: Bone windows stone fragility.
Filling defect
The collecting systems and ureters should be opacified on the excretory phase of CT urogram and adequate distension and opacification of the ureter and pelvicalyceal system are vital when evaluating the urothelium. Filling defects can be difficult to appreciate on abdominal windows and subtle filling defects are more clearly seen on bone window settings. This can allow ureteric neoplasms to be distinguished from other causes of filling defects. Figure 4 shows an example of a filling defect in the left ureter that is more clearly defined on bone windows compared with abdominal windows. This was a female patient who presented with cyclic pain and was found on biopsy to have endometriosis in the left ureter.

Figure 4a: Abdominal windows filling defect.

Figure 4b: Bone windows filling defect.
Conclusion
Viewing both CTKUB and excretory images of CTU on both abdominal and bone windows can be useful as small lesions or calculi may be obscured by the high attenuation contrast in the collecting systems and ureters but may be clearer seen on different window settings.
References
1. Yoshida S, Hayashi T, Okada T, et al. Discrimination between ureteral stent and stone by non-contrast helical computed tomography in the clinical setting. International Journal of Urology 2007;14(2):171-3.
2. Tanrikut C, Sahani D, Dretler SP. Distinguishing stent from stone: use of bone windows. Urology 2004;63(5):823-6.
3. Eisner BH, Kambadakone A, Monga M, et al. computerised tomography magnified bone windows are superior to standard soft tissue windows for accurate measurement of stone size: an in vitro and clinical study. Journal of Urology 2009;181(4):1810-715.
4. Williams JC, Paterson RF, Kopecky KK, et al. High resolution detection of internal structure of renal calculi by helical computerised tomography. J Urol 2002;167(1):322-6.
5. Zarse CA, Hameed TA, Jackson ME, et al. CT visible internal stone structure, but not Hounsfield unit value, of calcium oxalate monohydrate (COM) calculi predicts lithotripsy fragility in vitro. Urol Res 2007;35(4):201-6.

